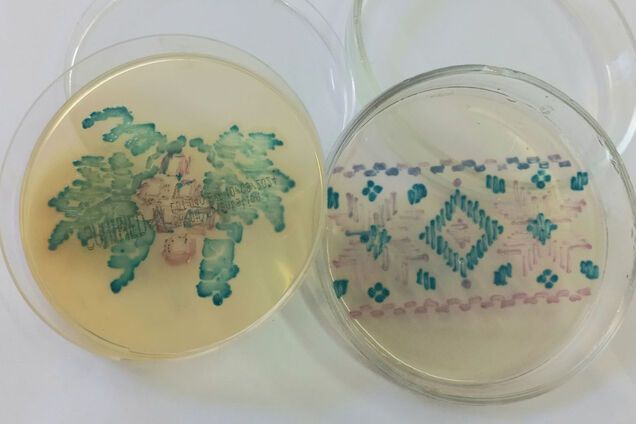
Украинка создала вышивку из бактерий: ученые это оценили. Фото

Вместо учебника – легкие и сердце: украинцев ошеломил урок биологии в 8 классе. Видео
Учительница принесла реальный экспонат для демонстрации ученикам
Что имеет худший запах в мире: выдержать очень трудно
Он заставляет людей бежать в панике и подозревать вмешательство сверхъестественных сил.
Дети учат строение митохондрии, сушат жуков и приносят скелеты рыбы. Лучший учитель Украины объяснил, что не так с уроками биологии в школе
Школьникам необходимы знания, которые они смогут использовать в жизни